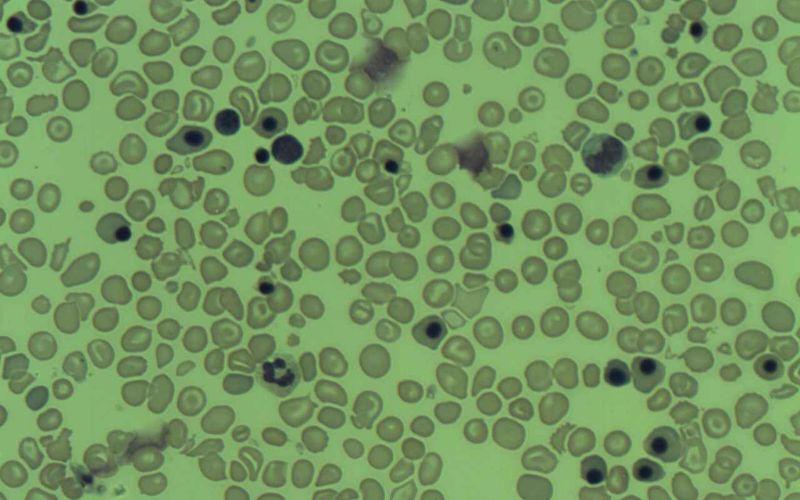

¿Qué son los eritroblastos?
Los eritroblastos son células precursoras de los eritrocitos de vertebrados. La disminución de la concentración de oxígeno en los tejidos, promoverá en estas células eventos de diferenciación celular que darán origen a eritrocitos maduros. El conjunto de todos estos eventos es conocido como eritropoyesis.
Durante la eritropoyesis se incrementa la síntesis de hemoglobina, proteína abundante en eritrocitos que media el suministro de oxígeno a los tejidos y la detoxificación de dióxido de carbono de los mismos, un producto de desecho de la respiración celular tóxico para las células.
La pérdida total del núcleo, así como de los organelos celulares, marca la culminación del proceso de eritropoyesis en células de vertebrados mamíferos. En el resto de vertebrados, como los reptiles, el núcleo persiste una vez terminado el proceso de diferenciación.
Errores en el proceso de diferenciación de los eritroblastos dan lugar a un conjunto de patologías sanguíneas que en su conjunto reciben el nombre de anemias megaloblásticas.
¿Qué son los eritrocitos?

Los eritrocitos, comúnmente conocidos como glóbulos rojos, son las células más abundantes en la sangre de los vertebrados.
Tienen una morfología característica similar a discos bicóncavos, y su función principal es la de llevar a cabo el transporte de oxígeno (O₂) a los diferentes tejidos del organismo, al mismo tiempo que los limpia del dióxido de carbono (CO₂) producido durante la respiración celular.
Este intercambio de CO₂ por O₂ es posible debido a que estas células albergan en su interior grandes cantidades de una proteína de color rojo, llamada hemoglobina, capaz de interactuar con ambas especies químicas a través de un grupo hemo presente en su estructura.
Una particularidad de estas células en mamíferos con respecto al resto de vertebrados es la carencia de núcleo y organelas citoplasmáticas. Sin embargo, durante las fases iniciales de producción en las primeras etapas del desarrollo embrionario, se ha observado que los precursores celulares a partir de los cuales se originan presentan un núcleo transitorio.
Esto último no resulta extraño, dado que las primeras fases del desarrollo de embriones suele ser similar en todos los vertebrados, divergiendo solo las etapas que corresponden a una mayor diferenciación.
Concepto de eritroblastos
Los eritroblastos son células que darán origen a los eritrocitos maduros luego de experimentar consecutivos eventos de diferenciación celular.
Estas células precursoras son originadas a partir de un progenitor mieloide, común en la médula ósea de vertebrados, como células nucleadas, provistas de núcleo y orgánulos celulares.
Cambios en el contenido de su citoplasma y en el rearreglo del citoesqueleto culminarán en la generación de eritrocitos listos para entrar en circulación. Estos cambios responden a estímulos medioambientales indicativos de la disminución de oxígeno en los tejidos y por ende una demanda en la producción de eritrocitos.
¿Qué es la eritropoyesis?
Eritropoyesis es proceso mediante el cual tiene lugar la producción y desarrollo de los glóbulos rojos, necesarios para mantener el abastecimiento de oxígeno a los diferentes órganos y tejidos.
Este proceso se encuentra finamente regulado por la acción de la eritropoyetina (EPO), una hormona de síntesis renal que a su vez se encuentra modulada por las concentraciones de oxígeno disponibles en los tejidos.
Concentraciones bajas de oxígeno tisular inducen la síntesis de EPO por el factor de transcripción inducible por hipoxia (HIF-1), la cual estimula la proliferación de eritrocitos mediante su unión a los receptores EpoR, presentes en las células precursoras de eritrocitos.
En mamíferos, la eritropoyesis es llevada a cabo en dos etapas, que llevan el nombre de eritropoyesis primitiva y eritropoyesis definitiva.
La primera ocurre en el saco vitelino durante el desarrollo embrionario, dando lugar a eritroblastos nucleados de gran tamaño, mientras que la segunda tiene lugar en el hígado fetal y continúa en la médula ósea después del segundo mes de gestación, generando eritrocitos enucleados de menor tamaño.
Otras proteínas, como la citocina antipoptótica Bcl-X, cuya transcripción es regulada por el factor de transcripción GATA-1, influencian de manera positiva el proceso de eritropoyesis. Además, el suministro de hierro, vitamina B12 y ácido fólico resultan también necesarios.
Diferenciación de eritroblastos en eritrocitos
En el proceso de eritropoyesis definitiva, los eritrocitos son formados en la médula ósea a partir de una célula progenitora no diferenciada, o progenitor mieloide común, capaz de dar origen a otras células como granulocitos, monocitos y plaquetas.
Esta célula debe recibir las señales extracelulares adecuadas para comprometer su diferenciación hacia el linaje eritroide.
Una vez adquirido este compromiso, se inicia una secuencia de eventos de diferenciación que comienza con la formación del pronormoblasto, también conocido como proeritroblasto, una célula precursora de eritroblastos, de gran tamaño y provista de núcleo.
Posteriormente, el proeritroblasto experimentará una disminución progresiva del volumen celular nuclear acompañada de un incremento en la síntesis de hemoglobina. Todos estos cambios ocurren lentamente mientras esta célula pasa por diferentes estadios celulares: el eritroblasto o normoblasto basófilo, eritroblasto policromático y eritroblasto ortocromático.
El proceso concluye con la pérdida total del núcleo, así como de las organelas presentes en el eritroblasto ortocromático, originando un eritrocito maduro.
Para llegar finalmente a esto, este último debe pasar por el estadio de reticulocito, una célula enucleada que aún contiene en su citoplasma organelos y ribosomas. La completa eliminación del núcleo y las organelas es ejecutada mediante exocitosis.
Los eritrocitos maduros salen de la medula ósea al torrente sanguíneo, donde permanecen circulando por un tiempo aproximado de 120 días, antes de ser engullidos por macrófagos. Por tanto, la eritropoyesis es un proceso que ocurre de manera continua a lo largo de la vida de un organismo.
Diferenciación celular de los eritroblastos
A medida que los eritoblastos avanzan hacia la completa diferenciación en un eritrocito maduro, experimentan múltiples cambios en su citoesqueleto, así como en la expresión de proteínas de adhesión celular.
Los microfilamentos de actina se despolimerizan y un nuevo citoesqueleto basado en espectrina se ensambla. La espectrina es una proteína periférica de membrana localizada en la cara citoplasmática que interactúa con la anquirina, una proteína que media la unión del citoesqueleto con la proteína transmembranal Banda 3.
Estos cambios en el citoesqueleto y en la expresión de receptores para Epo, así como los mecanismos que los modulan, resultan críticos para la maduración eritroide.
Esto se debe a que median el establecimiento de interacciones entre los eritroblastos y células presentes en el microambiente de la médula ósea, facilitando la transmisión de las señales necesarias para comenzar y dar por culminada la diferenciación.
Una vez finalizada la diferenciación, ocurren nuevos cambios que favorecen la pérdida de adhesión de las células a la médula y su liberación al torrente sanguíneo, donde cumplirán su función.
Patologías asociadas con errores en la diferenciación de eritroblastos
Errores durante la diferenciación de los eritroblastos en la médula ósea dan lugar a la aparición de patologías sanguíneas, como las anemias megaloblásticas. Estas tienen su origen en deficiencias en el suministro de vitamina B12 y folatos necesarios para promover la diferenciación de los eritroblastos.
El término “megaloblástica” hace alusión al gran tamaño que alcanzan los eritroblastos, e incluso los eritrocitos, como producto de una eritropoyesis ineficaz caracterizada por una síntesis de ADN defectuosa.
Referencias
- Ferreira, R., Ohneda, K., Yamamoto, M., Philipsen, S. Función GATA1, un paradigma para los factores de transcripción en la hematopoyesis. Molecular and Cellular Biology.
- Kingsley, P.D., Malik, J., Fantauzzo, K.A., Palis, J. Yolk sac-derived primitive erythroblasts enucleate during mammalian embryogenesis. Blood.
- Migliaccio, A.R. Erythroblast Enucleation. Haematologica.
- Skutelsky, E., Danon, D. An electron microscopic study of nuclear elimination from the late erythroblast. J. Cell Biol.
- Tordjman, R., Delaire, S., Plouet, J., Ting, S., Gaulard, P., Fichelson, S., Romeo, P., Lemarchandel, V. Erythroblasts are a source of angiogenic factors. Blood.